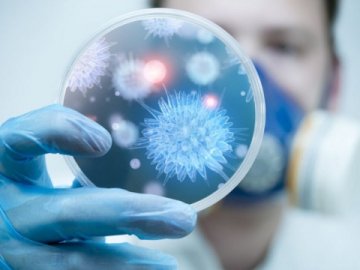
В Україні від грипу помер чоловік

В Україні від грипу помер чоловік
В Україні від ускладнень грипу померла людина.
Відомо, що чоловік із групи медичного ризику захворів 20 грудня 2019 року, а вірус грипу типу А встановили лабораторно. Незважаючи на проведені реанімаційні заходи, 31 грудня 2019 хворий помер, - інформує Центр громадського здоров’я України.
Зазначається, що з початку епідсезону госпіталізували 53 527 осіб, із них 79% - діти. З початку жовтня проти грипу вакцинували 227 417 осіб.
Нагадують, що найкраща профілактика грипу — щорічна вакцинація. Імунізація зменшує ймовірність захворіти на грип та ризики серйозних ускладнень, госпіталізації та смерті від захворювання.
Грип має симптоми, подібні до ознак ГРВІ, але набагато небезпечніші. За перших симптомів обов`язково звертайтеся до сімейного лікаря.
Бажаєте дізнаватися головні новини Луцька та Волині першими? Приєднуйтеся до нашого каналу в Telegram!
Відомо, що чоловік із групи медичного ризику захворів 20 грудня 2019 року, а вірус грипу типу А встановили лабораторно. Незважаючи на проведені реанімаційні заходи, 31 грудня 2019 хворий помер, - інформує Центр громадського здоров’я України.
Зазначається, що з початку епідсезону госпіталізували 53 527 осіб, із них 79% - діти. З початку жовтня проти грипу вакцинували 227 417 осіб.
Нагадують, що найкраща профілактика грипу — щорічна вакцинація. Імунізація зменшує ймовірність захворіти на грип та ризики серйозних ускладнень, госпіталізації та смерті від захворювання.
Грип має симптоми, подібні до ознак ГРВІ, але набагато небезпечніші. За перших симптомів обов`язково звертайтеся до сімейного лікаря.
Бажаєте дізнаватися головні новини Луцька та Волині першими? Приєднуйтеся до нашого каналу в Telegram!
Якщо Ви зауважили помилку, виділіть її та натисніть Ctrl+Enter для того, щоб повідомити про це редакцію
Коментарі 0
Останні новини
Мешканці двох багатоповерхівок у Луцьку сидять без гарячої води
03 січня, 2020, 12:28
Вийшли на ранкове прибирання: п'яний волинянин побив чотирьох двірників
03 січня, 2020, 12:22
В Україні від грипу помер чоловік
03 січня, 2020, 12:20
У Луцьку запрошують подивитися грандіозну виставу для дітей та дорослих «Снігова Королева»
03 січня, 2020, 12:15
Звільнився директор шахти №10 Нововолинська
03 січня, 2020, 12:04




